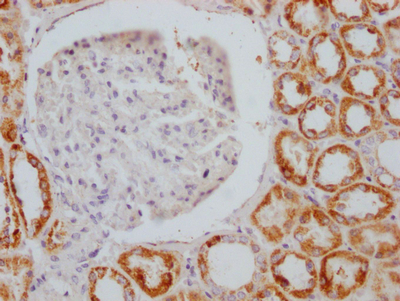

AIFM1 Recombinant Monoclonal Antibody
-
中文名稱:AIFM1重組抗體
-
貨號:CSB-RA296617A0HU
-
規格:¥3900
-
圖片:
-
Western Blot
Positive WB detected in: Hela whole cell lysate, Jurkat whole cell lysate, A549 whole cell lysate, HepG2 whole cell lysate, MCF-7 whole cell lysate, Rat liver tissue, Rat kidney tissue
All lanes: AIFM1 antibody at 1:2000
Secondary
Goat polyclonal to rabbit IgG at 1/50000 dilution
Predicted band size: 67, 36, 29, 27 kDa
Observed band size: 67 kDa -
IHC image of CSB-RA296617A0HU diluted at 1:100 and staining in paraffin-embedded human kidney tissue performed on a Leica BondTM system. After dewaxing and hydration, antigen retrieval was mediated by high pressure in a citrate buffer (pH 6.0). Section was blocked with 10% normal goat serum 30min at RT. Then primary antibody (1% BSA) was incubated at 4℃ overnight. The primary is detected by a Goat anti-rabbit IgG polymer labeled by HRP and visualized using 0.05% DAB.
-
IHC image of CSB-RA296617A0HU diluted at 1:100 and staining in paraffin-embedded human liver tissue performed on a Leica BondTM system. After dewaxing and hydration, antigen retrieval was mediated by high pressure in a citrate buffer (pH 6.0). Section was blocked with 10% normal goat serum 30min at RT. Then primary antibody (1% BSA) was incubated at 4℃ overnight. The primary is detected by a Goat anti-rabbit IgG polymer labeled by HRP and visualized using 0.05% DAB.
-
-
其他:
產品詳情
-
產品描述:CSB-RA296617A0HU AIFM1重組單克隆抗體是經ELISA、WB和IHC嚴格驗證的高特異性科研工具,適用于檢測凋亡誘導因子AIFM1的蛋白表達及分布。該抗體靶向的AIFM1蛋白作為線粒體關鍵調控因子,通過介導Caspase非依賴性凋亡通路參與細胞程序性死亡,同時在維持線粒體膜結構及能量代謝中發揮重要作用。實驗數據顯示,在Western Blot中該抗體在推薦稀釋度1:500-1:5000范圍內可清晰識別內源性AIFM1蛋白,且無交叉反應;免疫組化應用(1:50-1:200)能準確呈現線粒體定位的亞細胞分布特征,與蛋白功能特性高度吻合。本產品適用于神經退行性疾病模型、缺血再灌注損傷等細胞凋亡機制研究,也可用于線粒體形態與功能相關性分析、藥物誘導凋亡效應評估等實驗體系,為探究AIFM1在代謝調控、氧化應激響應及病理狀態下的分子機制提供可靠檢測方案。
-
Uniprot No.:
-
基因名:
-
別名:Apoptosis-inducing factor 1, mitochondrial (EC 1.1.1.-) (Programmed cell death protein 8), AIFM1, AIF PDCD8
-
反應種屬:Human, Rat
-
免疫原:A synthesized peptide derived from human AIF
-
免疫原種屬:Homo sapiens (Human)
-
標記方式:Non-conjugated
-
克隆類型:Monoclonal
-
抗體亞型:Rabbit IgG
-
純化方式:Affinity-chromatography
-
克隆號:4B2
-
濃度:It differs from different batches. Please contact us to confirm it.
-
保存緩沖液:Rabbit IgG in 10mM phosphate buffered saline , pH 7.4, 150mM sodium chloride, 0.05% BSA, 0.02% sodium azide and 50% glycerol.
-
產品提供形式:Liquid
-
應用范圍:ELISA, WB, IHC
-
推薦稀釋比:
Application Recommended Dilution WB 1:500-1:5000 IHC 1:50-1:200 -
Protocols:
-
儲存條件:Upon receipt, store at -20°C or -80°C. Avoid repeated freeze.
-
貨期:Basically, we can dispatch the products out in 1-3 working days after receiving your orders. Delivery time maybe differs from different purchasing way or location, please kindly consult your local distributors for specific delivery time.
-
用途:For Research Use Only. Not for use in diagnostic or therapeutic procedures.
相關產品
靶點詳情
-
功能:Functions both as NADH oxidoreductase and as regulator of apoptosis. In response to apoptotic stimuli, it is released from the mitochondrion intermembrane space into the cytosol and to the nucleus, where it functions as a proapoptotic factor in a caspase-independent pathway. The soluble form (AIFsol) found in the nucleus induces 'parthanatos' i.e. caspase-independent fragmentation of chromosomal DNA. Binds to DNA in a sequence-independent manner. Interacts with EIF3G, and thereby inhibits the EIF3 machinery and protein synthesis, and activates caspase-7 to amplify apoptosis. Plays a critical role in caspase-independent, pyknotic cell death in hydrogen peroxide-exposed cells. In contrast, participates in normal mitochondrial metabolism. Plays an important role in the regulation of respiratory chain biogenesis by interacting with CHCHD4 and controlling CHCHD4 mitochondrial import.; Has NADH oxidoreductase activity. Does not induce nuclear apoptosis.; Pro-apoptotic isoform.
-
基因功能參考文獻:
- Here, the binding site of AIF(Delta1-121) and AIF(370-394) on CypA has been mapped by NMR spectroscopy and biochemical studies, and a molecular model of the complex has been proposed. The authors show that AIF(370-394) interacts with CypA on the same surface recognized by AIF(Delta1-121) protein and that the region is very close to the CypA catalytic pocket. PMID: 28442737
- new form of motor neuropathy expands the phenotypic spectrum of AIFM1 mutations and therefore, the AIFM1 gene should be considered in the diagnosis of hereditary motor neuropathies PMID: 28975462
- X-linked hypomyelination with spondylometaphyseal dysplasia associated with mutations in AIFM1 PMID: 28842795
- report of a family carrying a novel missense mutation in AIFM1 that exhibits an isolated axonal polyneuropathy with misassembly of mitochondrial complex I and III. PMID: 28888069
- we sought to investigate mechanisms mediated by Hsp70 acetylation in relation to apoptotic and autophagic programmed cell death. Upon stress-induced apoptosis, Hsp70 acetylation inhibits apoptotic cell death, mediated by Hsp70 association with apoptotic protease-activating factor (Apaf)-1 and apoptosis-inducing factor (AIF), key modulators of caspase-dependent and -independent apoptotic pathways, respectively PMID: 28627586
- Overexpression of full-length AIFM1 suppresses proliferation and induces apoptosis of HepG2 and Hep3B cells. Caspase 3 and DRAM are involved in full-length AIFM1-induced apoptosis in HepG2 and Hep3B cells. PMID: 29501488
- Real-time PCR results showed that apoptosis-inducing factor (AIF) and calpain-1 mRNAs were highly expressed in the transitional segmentof the Hirschsprung's disease bowel, whereas autophagy protein 5 (Atg5) was highly expressed in the narrow segment. Western blot results were consistent with mRNA levels, with increased AIF, calpain-1, and Atg5 expressions in the transitional segment compared with the dilated segment. PMID: 28562483
- Data revealed that under a nutrient deficient condition, CD317 functions as an anti-apoptotic factor through AIF-mediated caspase and autophagy-independent manner. PMID: 27444183
- we report that AIF-independent PARP-1-dependent necrosis constitutes a major mechanism of RPE cell death leading to retinal degeneration in dry age-related macular degeneration . PMID: 28055012
- Downregulation of AIF by hypoxia causes oxidative inactivation of the lipid phosphatase activity of phosphatase and tensin homolog on chromosome 10 (PTEN), with ensuing activation of Akt kinase, phosphorylation of the Akt substrate GSK-3beta and activation of WNT/beta-catenin signaling in colon cancer cells. PMID: 27543779
- novel pathway for mda-7/IL-24-induced caspase-independent apoptosis in neuroblastoma cells mediated through modulation of AIF, ATM, and gamma-H2AX. PMID: 27197168
- Study defines the mechanism whereby AIF is allosterically modulated by charge-complex formation with NADH. Two distinct molecular pathways couple AIF's active site to dimerization and release of its regulatory C-loop insert with implications for AIF allosteric switching in cell survival and death. PMID: 27818101
- Whole exome sequencing indicated a single plausible candidate - the p.Asp237Gly variant in apoptosis inducing factor mitochondria associated 1 (AIFM1; chr. Xq26.1), and the p.Asp237Gly segregated with disease in two families. PMID: 27102849
- Only a drastic decrease in the expression level or/and redox activity of AIF tends to cause an early and severe neurodegeneration, whereas less pronounced changes in the AIF properties could lead to a broad range of slowly progressive neurological disorders. PMID: 27178839
- AIF translocation plays a role in influenza-virus-induced apoptosis. PMID: 27853862
- Copper induces the activation of apoptosis through casp3/casp8/casp9/AIF/TP53 signaling pathways. Suggest that apoptosis activation mechanism is dependent on the concentration, time of exposure to Cu and cell type. PMID: 27046389
- Estradiol inhibits oxidative stress-induced accumulation of AIF in nucleolus and PARP1-dependent cell death via estrogen receptor alpha in MCF-7 cells. PMID: 25280774
- AIF may participate in but not be dominant in the process of retinal pigment epithelium cell apoptosis induced by oxidative stress. PMID: 27453270
- Altogether these data indicate that AIF supports the growth and survival of metabolically defined pancreatic cancer cells and that this metabolic function may derive from a novel mechanism so far undocumented in other cancer types. PMID: 27108222
- Cdk5-mediated phosphorylation of CHIP negatively regulates its neuroprotective function, thereby contributing to truncated AIF mediated neuronal cell death progression following neurotoxic stimuli. PMID: 26206088
- Results identify PTEN as the substrate of AIF oxidoreductase and reveal a novel function for AIF in controlling tumor metastasis. PMID: 26415504
- UDA decreased the St-induced changes in mitochondrial and cytosolic AIF level, whereas in Dox-model it affected only the cytosolic AIF content. PMID: 26012840
- strongly support a direct relationship between AIF nuclear translocation and radiation induced cell death in hepatocellular carcinoma cell line HepG2 PMID: 26920061
- identification of the novel interaction between Trx1 and AIF has provided opportunities to design and develop therapeutically relevant strategies that either promote or prevent this protein-protein interaction for the treatment of different disease PMID: 26119781
- AIF bears a HSP-70 binding domain allowing association with HSP-70. PMID: 26165468
- Missense mutations in AIFM1 are associated with X-linked recessive auditory neuropathy spectrum disorder. PMID: 25986071
- AIF and its family member protein, AMID, are rotenone-sensitive NADH:ubiquinone oxidoreductases (of the NDH-2 type). PMID: 26063804
- Summarizing what is known today, mutations in AIFM1 are associated with a progressive disorder with myopathy, ataxia and neuropathy. PMID: 25583628
- These results suggest that AIF downregulation is a common event in kidney tumor development. AIF loss may lead to decreased STK3 activity, defective apoptosis and malignant transformation PMID: 24992339
- Residues Regulating the Reductase Activity of the Human Mitochondrial Apoptosis Inducing Factor PMID: 26237213
- Data indicate that poptosis-inducing factor (AIF) controls the mitochondrial import of mitochondrial membrane transport protein CHCHD4. PMID: 26004228
- review describes the multistep course of parthanatos and its dependence on PAR signalling and nuclear AIF translocation. PMID: 24684389
- Increased trophoblast apoptosis and altered expression levels of syncytin-1, calpain 1, and AIF is observed in preeclamptic placentas. PMID: 24413738
- Inhibition of the AIF/CypA complex protects against intrinsic death pathways induced by oxidative stress. PMID: 24434516
- both the mitochondrial and apoptotic functions of hAIF are interconnected and coenzyme controlled: a key information in the understanding of the physiological role of AIF in the cellular life and death cycle. PMID: 24914854
- The E1B-55K or E4orf3 proteins independently prevented nuclear fragmentation subsequent to release of AIF from the mitochondria, possibly by altering the intracellular distribution of PAR-modified proteins. PMID: 24889240
- Data show that buthionine sulfoximine and synergizes with hydroxychavicol in inducing apoptosis of chronic myeloid leukemic (CML) cells through the GSH-ROS-JNK-ERK-iNOS pathway by apoptosis inducing factor (AIF)-dependent manner. PMID: 24040019
- Aif seems to have pro-apoptotic and anti-apoptotic roles in the same lineage in different contexts and at different stages PMID: 24434313
- Bit1 plays pivotal roles in the development and progression of ESCC, and its biological functions in ESCC may be closely associated with AIF and Bcl-2 levels. PMID: 23955799
- Apoptosis-inducing factor and leukocyte elastase inhibitor derived DNase II interact and can cooperate to induce cell death. PMID: 23673989
- The diarylheptanoid hirsutenone sensitizes chemoresistant ovarian cancer cells to cisplatin via modulation of apoptosis-inducing factor and X-linked inhibitor of apoptosis. PMID: 24247248
- the caspase-independent mitochondrial apoptosis factor, apoptosis-inducing factor (AIF) was upregulated following SPG treatment. These findings indicate that SPG exerts its anticancer effects on RC-58T/h/SA#4 primary prostate cancer cells PMID: 23443329
- Calpain activation via Ca(2) flux plays an essential role in eliciting an AIF-mediated, caspase-independent apoptotic pathway in EV71-infected cells. PMID: 23515028
- AIF knockdown disrupts function of complex I and therefore increases the superoxide production in mitochondria PMID: 23682427
- Taken together our results demonstrate that parthenolide causes in the two cell lines a caspase-independent cell death, which is mediated by AIF(apoptosis-inducing factor ). PMID: 22688575
- AIF is an important factor for advanced prostate cancer cells and that through control of energy metabolism and redox balance, the enzymatic activity of AIF is critical for this support. PMID: 23118229
- Our findings expand the spectrum of AIF-related disease and provide insight into the effects of AIFM1 mutations. PMID: 23217327
- We found AIF to be strongly expressed in the villous trophoblast and that small amounts of AIF were localized to the nucleus of the cells. PMID: 22133578
- AIF is imported from the endoplasmic reticulum to the mitochondria via mitochondria-associated membranes and transport vesicles. PMID: 22134679
- Different mechanisms preserve translation of programmed cell death 8 and JunB in poliovirus-infected endothelial cells. PMID: 22328780
顯示更多
收起更多
-
相關疾病:Combined oxidative phosphorylation deficiency 6 (COXPD6); Cowchock syndrome (COWCK); Deafness, X-linked, 5 (DFNX5)
-
亞細胞定位:Mitochondrion intermembrane space. Mitochondrion inner membrane. Cytoplasm. Nucleus. Cytoplasm, perinuclear region.; [Isoform 3]: Mitochondrion intermembrane space. Mitochondrion inner membrane.; [Isoform 4]: Mitochondrion. Cytoplasm, cytosol.; [Isoform 5]: Cytoplasm.
-
蛋白家族:FAD-dependent oxidoreductase family
-
組織特異性:Expressed in all tested tissues. Detected in muscle and skin fibroblasts (at protein level). Expressed in osteoblasts (at protein level).; [Isoform 3]: Brain specific.; [Isoform 4]: Expressed in all tested tissues except brain.; [Isoform 5]: Isoform 5 is
-
數據庫鏈接:
Most popular with customers
-
-
YWHAB Recombinant Monoclonal Antibody
Applications: ELISA, WB, IHC, IF, FC
Species Reactivity: Human, Mouse, Rat
-
Phospho-YAP1 (S127) Recombinant Monoclonal Antibody
Applications: ELISA, WB, IHC
Species Reactivity: Human
-
-
-
-
-